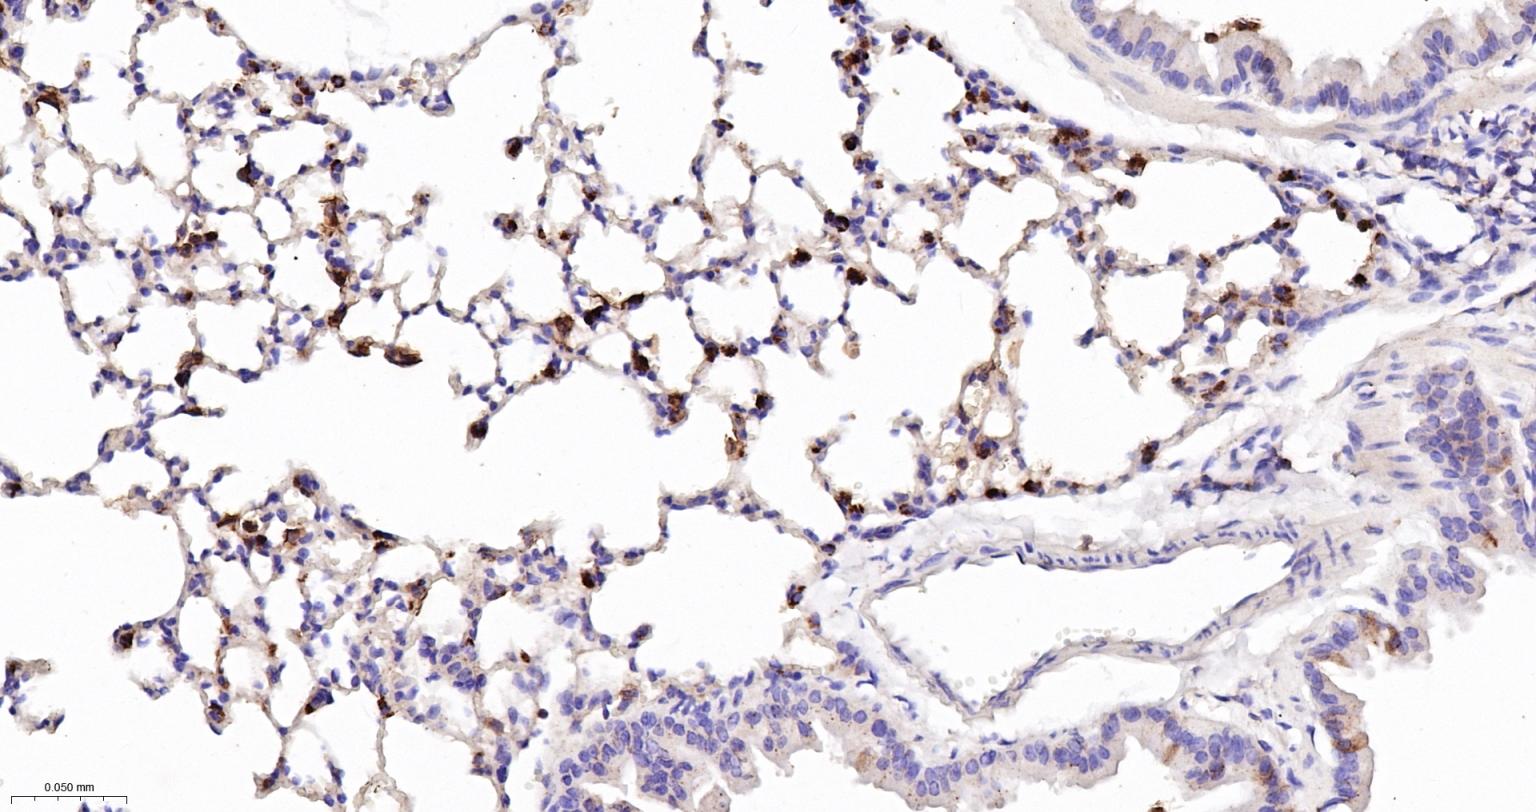
溶菌酶重组兔单抗
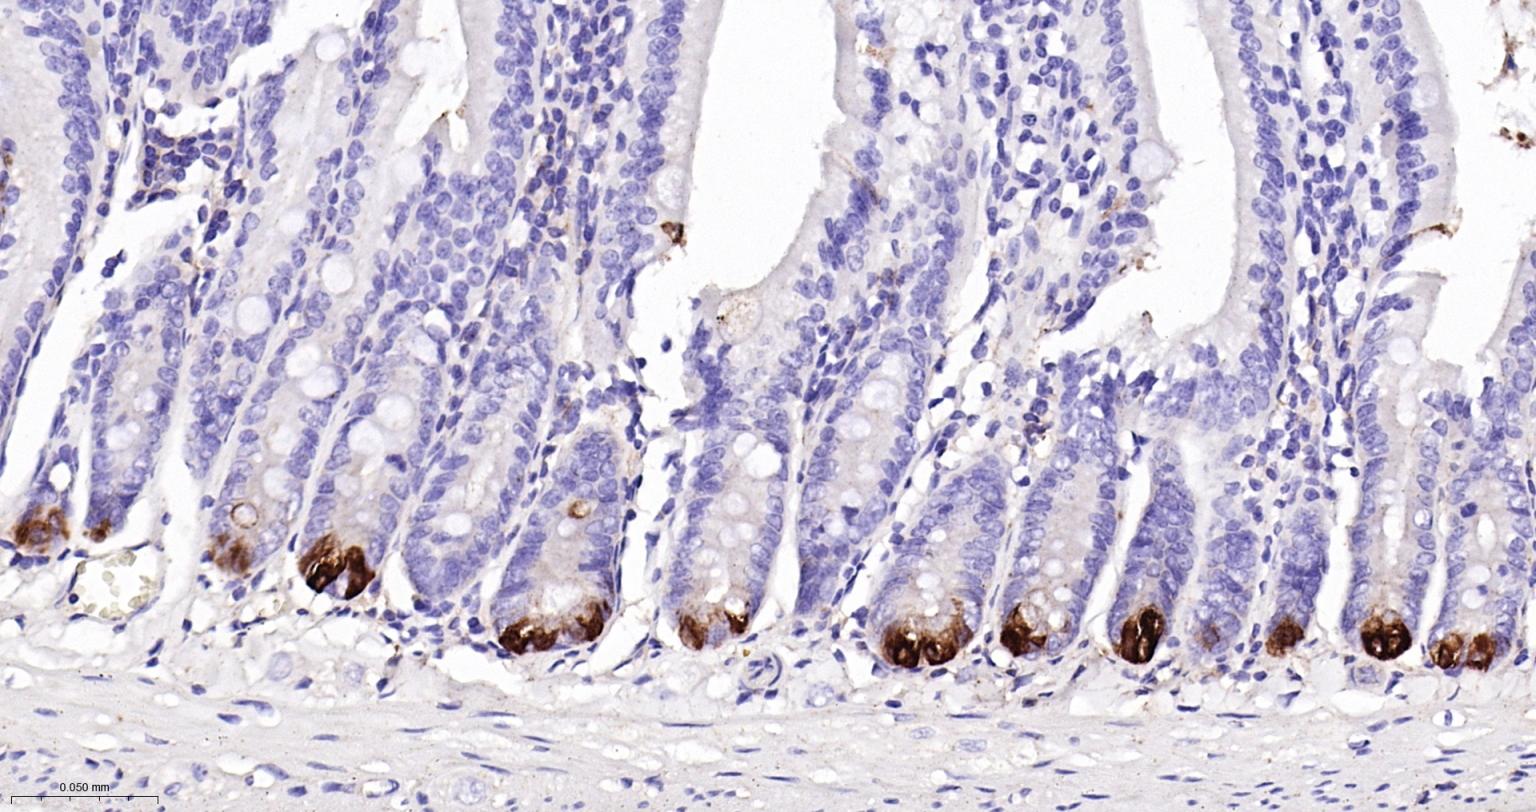
溶菌酶重组兔单抗

Lysozyme Recombinant Rabbit mAb (一抗) - WB,IHC-P,IHC-F,IF | Bioss
Rrmab?兔单抗

货号:bsm-60643R
产品详情
相关标记
相关产品
相关文献
常见问题
概述
产品编号
bsm-60643R
产品类型
重组兔单抗、mIHC精品抗体
英文名称
Lysozyme Recombinant Rabbit mAb
中文名称
溶菌酶重组兔单抗
英文别名
AMYLD5; LYZF1; LZM; LYSC_HUMAN; LYZ; 1,4-beta-N-acetylmuramidase C; 3.2.1.17;
抗体来源
Rabbit
免疫原
A synthesized peptide derived from human Lysozyme C: 50-84
亚型
IgG
性状
Liquid
纯化方法
affinity purified by Protein A
克隆类型
Recombinant
克隆号
8F12
CAS
12650-88-3
理论分子量
17 kDa
检测分子量
12 kDa
浓度
1mg/ml
储存液
0.01M TBS (pH7.4) with 1% BSA, 0.02% Proclin300 and 50% Glycerol.
研究领域
SWISS
Gene ID
保存条件
Shipped at 4℃. Store at -20℃ for one year. Avoid repeated freeze/thaw cycles.
注意事项
This product as supplied is intended for research use only, not for use in human, therapeutic or diagnostic applications.
产品介绍
溶菌酶(lysozyme )又称细胞壁质酶(muramidase)或n-乙酰胞壁质聚糖水解酶(n-acetylmuramideglycanohydralase)。
对于哺乳动物溶菌酶,其牛、猪、猫、兔、猴、马、羊等动物的乳汁中分离出溶菌酶,其化学性质与人溶菌酶相似。
溶菌酶作为机体非特异免疫因子之一,参与机体多种免疫反应,在机体正常防御功能和非特异免疫中,具有保持机体生理平衡的重要作用。可改善和增强巨嗜细胞吞噬和消化功能,激活白细胞吞噬功能,并能改善细胞抑制剂所导致的白细胞减少,从而增强机体的抵抗力。
对于哺乳动物溶菌酶,其牛、猪、猫、兔、猴、马、羊等动物的乳汁中分离出溶菌酶,其化学性质与人溶菌酶相似。
溶菌酶作为机体非特异免疫因子之一,参与机体多种免疫反应,在机体正常防御功能和非特异免疫中,具有保持机体生理平衡的重要作用。可改善和增强巨嗜细胞吞噬和消化功能,激活白细胞吞噬功能,并能改善细胞抑制剂所导致的白细胞减少,从而增强机体的抵抗力。
背景资料
This gene encodes human lysozyme, whose natural substrate is the bacterial cell wall peptidoglycan (cleaving the beta[1-4]glycosidic linkages between N-acetylmuramic acid and N-acetylglucosamine). Lysozyme is one of the antimicrobial agents found in human milk, and is also present in spleen, lung, kidney, white blood cells, plasma, saliva, and tears. The protein has antibacterial activity against a number of bacterial species. Missense mutations in this gene have been identified in heritable renal amyloidosis. [provided by RefSeq, Oct 2014]

产品应用
| 应用 | 已检合格种属 | 预测种属 | 推荐稀释比例 |
|---|---|---|---|
| WB | Human, Mouse | 1:500-2000 | |
| IHC-P | Human, Mouse | 1:100-500 | |
| IHC-F | Human, Mouse | 1:100-500 | |
| IF | Human, Mouse | 1:100-500 |
交叉反应
交叉反应: Human, Mouse
相关产品
暂无相关产品
靶标
基因名
LYZ
蛋白名
Lysozyme C
亚细胞定位
Secreted.
疾病
Defects in LYZ are a cause of amyloidosis type 8 (AMYL8) [MIM:105200]; also known as systemic non-neuropathic amyloidosis or Ostertag-type amyloidosis. AMYL8 is a hereditary generalized amyloidosis due to deposition of apolipoprotein A1, fibrinogen and lysozyme amyloids. Viscera are particularly affected. There is no involvement of the nervous system. Clinical features include renal amyloidosis resulting in nephrotic syndrome, arterial hypertension, hepatosplenomegaly, cholestasis, petechial skin rash.
相似性
Belongs to the glycosyl hydrolase 22 family.
同靶标产品
相关文献
提示: 发表研究结果有使用 bsm-60643R 时请让我们知道,以便我们可以引用参考文章。作为回馈,资料提供者将获得我们送上的小礼品。